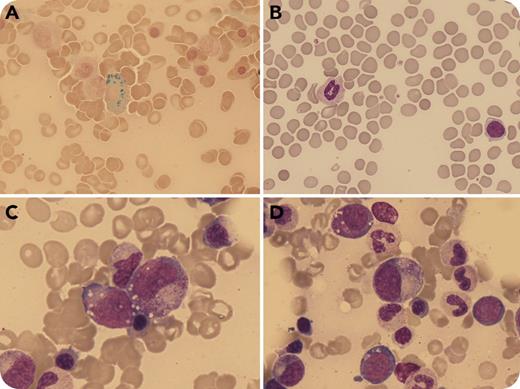
An 81-year-old man nourished exclusively by percutaneous endoscopic gastrostomy (PEG) due to complications following surgery was referred for macrocytic anemia and cutaneous hypersensitivity. The laboratory results were as follows: hemoglobin level 8.6 g/dL, mean corpuscular volume (MCV) 99 μL, reticulocytes 2.65%, platelet count 160 × 109/L, white blood cell count 4.5 × 109/L. Serum levels of vitamin B12, red blood cell folate, and thyrotropin were normal. The erythropoietin level was 65 U/L, and the ferritin level was 1189 ng/mL. The peripheral blood showed hyposegmented, hypogranular neutrophils (panel B; original magnification ×600, May-Grünwald-Giemsa stain). Bone marrow aspirate showed dyserythropoiesis, cytoplasmic vacuoles within erythroid and myeloid precursors (panels C-D; original magnification ×600, May-Grünwald-Giemsa stain), and increased plasma cells, some with irregular cytoplasmic contours. Perls staining showed iron in the plasma cells (panel A; original magnification ×600). Flow cytometry and cytogenetics were normal. These findings suggested copper deficiency, confirmed by a serum level of <3 μL/dL (reference range, 70-140 μL/dL) and a low 24-hour urine level. Zinc levels were normal. / After 2 months of copper supplementation via PEG, the hemoglobin level improved to 11 g/dL with an MCV of 89 fL and a serum copper level of 68 μL/dL. Neurologic symptoms improved. Copper deficiency may cause cytopenias and dysplasia, leading to misdiagnosis as myelodysplastic syndrome due to dyserythropoiesis, dysmyelopoiesis, and ringed sideroblasts. The presence of intracytoplasmic vacuoles in erythroid and myeloid precursors and of iron-containing plasma cells should prompt evaluation for copper deficiency.

An 81-year-old man nourished exclusively by percutaneous endoscopic gastrostomy (PEG) due to complications following surgery was referred for macrocytic anemia and cutaneous hypersensitivity. The laboratory results were as follows: hemoglobin level 8.6 g/dL, mean corpuscular volume (MCV) 99 μL, reticulocytes 2.65%, platelet count 160 × 109/L, white blood cell count 4.5 × 109/L. Serum levels of vitamin B12, red blood cell folate, and thyrotropin were normal. The erythropoietin level was 65 U/L, and the ferritin level was 1189 ng/mL. The peripheral blood showed hyposegmented, hypogranular neutrophils (panel B; original magnification ×600, May-Grünwald-Giemsa stain). Bone marrow aspirate showed dyserythropoiesis, cytoplasmic vacuoles within erythroid and myeloid precursors (panels C-D; original magnification ×600, May-Grünwald-Giemsa stain), and increased plasma cells, some with irregular cytoplasmic contours. Perls staining showed iron in the plasma cells (panel A; original magnification ×600). Flow cytometry and cytogenetics were normal. These findings suggested copper deficiency, confirmed by a serum level of <3 μL/dL (reference range, 70-140 μL/dL) and a low 24-hour urine level. Zinc levels were normal.
After 2 months of copper supplementation via PEG, the hemoglobin level improved to 11 g/dL with an MCV of 89 fL and a serum copper level of 68 μL/dL. Neurologic symptoms improved. Copper deficiency may cause cytopenias and dysplasia, leading to misdiagnosis as myelodysplastic syndrome due to dyserythropoiesis, dysmyelopoiesis, and ringed sideroblasts. The presence of intracytoplasmic vacuoles in erythroid and myeloid precursors and of iron-containing plasma cells should prompt evaluation for copper deficiency.
An 81-year-old man nourished exclusively by percutaneous endoscopic gastrostomy (PEG) due to complications following surgery was referred for macrocytic anemia and cutaneous hypersensitivity. The laboratory results were as follows: hemoglobin level 8.6 g/dL, mean corpuscular volume (MCV) 99 μL, reticulocytes 2.65%, platelet count 160 × 109/L, white blood cell count 4.5 × 109/L. Serum levels of vitamin B12, red blood cell folate, and thyrotropin were normal. The erythropoietin level was 65 U/L, and the ferritin level was 1189 ng/mL. The peripheral blood showed hyposegmented, hypogranular neutrophils (panel B; original magnification ×600, May-Grünwald-Giemsa stain). Bone marrow aspirate showed dyserythropoiesis, cytoplasmic vacuoles within erythroid and myeloid precursors (panels C-D; original magnification ×600, May-Grünwald-Giemsa stain), and increased plasma cells, some with irregular cytoplasmic contours. Perls staining showed iron in the plasma cells (panel A; original magnification ×600). Flow cytometry and cytogenetics were normal. These findings suggested copper deficiency, confirmed by a serum level of <3 μL/dL (reference range, 70-140 μL/dL) and a low 24-hour urine level. Zinc levels were normal.
After 2 months of copper supplementation via PEG, the hemoglobin level improved to 11 g/dL with an MCV of 89 fL and a serum copper level of 68 μL/dL. Neurologic symptoms improved. Copper deficiency may cause cytopenias and dysplasia, leading to misdiagnosis as myelodysplastic syndrome due to dyserythropoiesis, dysmyelopoiesis, and ringed sideroblasts. The presence of intracytoplasmic vacuoles in erythroid and myeloid precursors and of iron-containing plasma cells should prompt evaluation for copper deficiency.
For additional images, visit the ASH Image Bank, a reference and teaching tool that is continually updated with new atlas and case study images. For more information, visit http://imagebank.hematology.org.